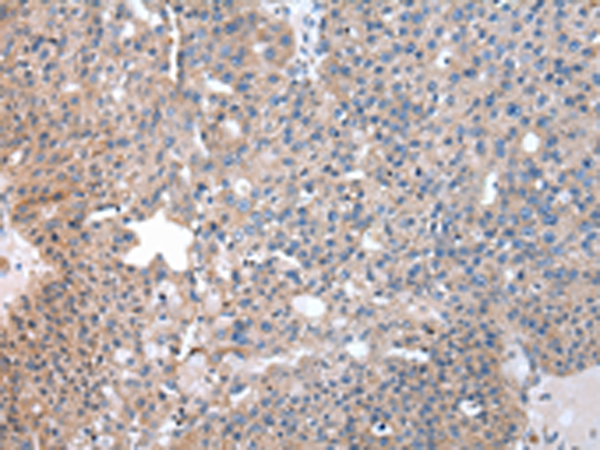
一抗

|
Background: |
Functions as a bridging factor between STAT6 and the basal transcription factor. Plays a role in PIM1 regulation of MYB activity. Functions as a transcriptional coactivator for the Epstein-Barr virus nuclear antigen 2 (EBNA2). |
|
Applications: |
WB, IHC |
|
Name of antibody: |
SND1 |
|
Immunogen: |
Fusion protein of human SND1 |
|
Full name: |
staphylococcal nuclease and tudor domain containing 1 |
|
Synonyms: |
p100; TDRD11 |
|
SwissProt: |
Q7KZF4 |
|
IHC positive control: |
Human breast cancer |
|
IHC Recommend dilution: |
25-100 |
|
WB Predicted band size: |
102 kDa |
|
WB Positive control: |
Hela and Jurkat cell, mouse liver tissue, hepg2, A172 and NIH/3T3 cell |
|
WB Recommended dilution: |
1000-5000 |


 購物車
購物車 幫助
幫助
 021-54845833/15800441009
021-54845833/15800441009